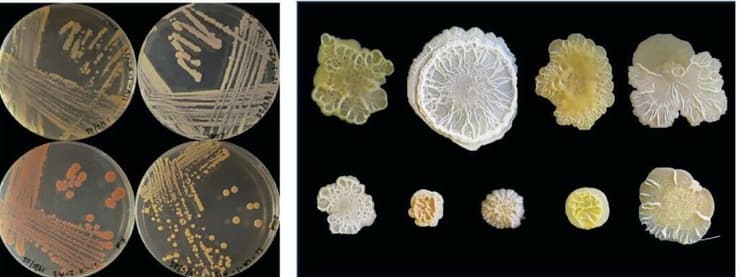
מתוך המחקר

חיידקים שורדים בסופות אבק המגיעות מאפריקה לישראל, ועשויים להשפיע על בריאות האדם והסביבה. כך עולה ממחקר חדש, שערכו ד"ר אילנה קולודקין-גל, מרצה בכירה במכון סקוג'ן לביולוגיה סינטטית באוניברסיטת רייכמן, וד"ר נעמה לאנג-יונה מהפקולטה להנדסה אזרחית וסביבתית בטכניון.
אובך ברמת גן. ארכיון
(צילום: אורן רייס)
החוקרות מצאו כי חיידקים מסוגלים "לארגן את עצמם" בתוך גרגרי האבק הנישאים בסערות אבק במבנים מיקרוסקופיים. מבנים אלה מגינים עליהם מפני יובש, קרינה קיצונית ומחסור חמור בחומרי הזנה, ומאפשרים להם לשרוד את המסע הארוך באוויר הפתוח. בתוך אותם גרגרים מתפתחות קהילות חיידקים מתוחכמות, עם חלוקת עבודה ביולוגית בין פרטים שונים ואף תקשורת כימית מורכבת, וזאת בתוך נישה זעירה ומשותפת.
שתי החוקרות נפגשו בתוכנית נשים במדע של מכון וייצמן, והחליטו לחבור יחד למחקר משותף. ד"ר לאנג-יונה חקרה במשך שנים את האפשרות של מעבר החומר התורשתי של החיידקים באוויר, ואילו המעבדה של ד"ר לאנג-יונה עסקה בחקר המיקרוביום שנמצא באטמוספרה, והיא ערכה תצפיות ודיגום של סופות אבק בחודשי האביב והסתיו. באנליזה של הדנ"א והרנ"א של אוכלוסיות החיידקים, גילתה החוקרת מהטכניון משפחה אחת של חיידקים מעניינים במיוחד.
"סופות חול הן סביבה מאוד קיצונית. היובש גדול ורוחות חזקות גורמות להסעת החלקיקים לאוויר", הסבירה ד"ר קולודקין-גל. "מדובר בסביבה דלה מאוד בחומרי הזנה, החשופה לקרינה חזקה". העובדה שד"ר לאנג-יונה הבינה שהחיידקים אכן מצליחים להתקיים באוויר, ובתנאים כה קשים, הובילה לשיתוף פעולה, שכן החוקרת מאוניברסיטת רייכמן חקרה את חיידק הבצילוס סבטיליס, שממצאים מהמעבדה רמזו כי הוא פעיל.
3 צפייה בגלריה


תחנת המחקר על גג אחד הבניינים בטכניון בזמן סופת אבק
(צילום: מעבדות לנג-יונה וקולודקין-גל)
החוקרות המשיכו לדגום סערות אבק, כאשר את איסוף הדגימות ביצעו באמצעות רחפן מיוחד שהוצב על גג הבניין של מחלקת ההנדסה האזרחית והסביבתית בטכניון. אפיון החיידקים נעשה יחד במעבדות של ד"ר קולודקין-גל ולנג-יונה. בזמני סופות חול ישנה מאסה קריטית של חלקיקים שניתן לדגום, ולכן בכל סערה הן יצאו לחקור.
"אף אחד לא האמין שחיידקים חיים שם ומתחלקים. ודווקא החיידקים בהם אני מתמחה ידועים ביכולתם לשרוד בסביבות קיצוניות. בחיידק הבצילוס סבטיליס משתמשים בנאס"א כדי להכשיר מסעות לחלל. הוא אחד החיידקים הפופלאריים בגלל יכולתו לשרוד מסעות בחלל", אמרו החוקרות.
לאחר איסוף דגימות האבק, החלו החוקרות בביצוע ניסויים בדגימות. "באוויר אין אפשרות לתת לחיידק מקור של נוטריינטים, והעובדה שחיידקים מצליחים לשרוד שם היא לא טריוויאלית. יש כנראה יש טריפה של חיידקים, ועוד נותר לחקור את הנושא. זו נישה לא מוכרת. בעצם, עושר המינים בסופות האבק, כולל מיני פטריות, הוא גדול. יש קבוצות של משפחות שחלקן טובות לנו, ויש סיכוי שחלקן רעות לנו. ככל שנבין יותר טוב מה אנחנו נושמים וכיצד הוא שורד, נבין את ההשפעה של זה על הבריאות שלנו".
בעצם, הממצאים של החוקרות משנים את ההבנה הקיימת לגבי יחסי הגומלין בין המיקרוביום לסביבה, ומצביע על כך שהאוויר שאנו נושמים עשוי להכיל קהילות שלמות של חיידקים שמקורם באזורים רחוקים – קהילות שמביאות עמן תכונות גנטיות חדשות, שיכולות להשתלב במערכות אקולוגיות טבעיות ובאדם.
"סופות האבק אינן רק תופעה מטאורולוגית", מסבירה ד"ר קולודקין-גל. "הן משמשות נתיב תחבורה לחיידקים עמידים במיוחד. החיידקים הללו מגיעים לסביבה האנושית כשהם נושאים גנים חדשים, שעשויים להשפיע על המיקרוביום שלנו ואף להועיל לו. מדובר בתגלית שפותחת אפשרויות חדשות לשימוש בחיידקים אלה ברפואה, בחקלאות ובתעשיות ירוקות".
החוקרות סבורות כי הסלקציה שמתרחשת במהלך סופות האבק "מעדיפה" את הזנים החדשניים יותר – תופעה שיכולה לתרום באופן ישיר לשיפור יישומיו של חיידק זה בתחומים רבים, שכבר משתמשים בו בחקלאות ובפרוביוטיקה רפואית.
לדברי החוקרות, הבנת מנגנוני ההישרדות והאינטראקציה של החיידקים בסביבה כה קיצונית תסייע להעריך את השפעתם הפוטנציאלית על מערכות טבעיות ותרבותיות, כולל השפעה על דרכי הנשימה ובריאות האדם.
"לפי התחזיות סופות האבק יגדלו ויהפכו לתכופות יותר ועוצמתיות יותר", אומרת לאנג-יונה . "הן מביאות איתן חיידקים בכמות גדולה ועם יכולות מענייניות. יש פה פוטנציאל שמשפיע על האקולוגיה, וזה מה שאנחנו מנסות להבין במעבדה. לחיידקים שיכולים לשרוד בתנאים קשים כל כך יכול להיות פוטנציאל ביו-טכנולוגי מעניין מאוד. זה פתח חדש שגורם לנו להסתכל על היכולות המיוחדות שלהם- ואיך יוכלו להיות לנו שימושיים".